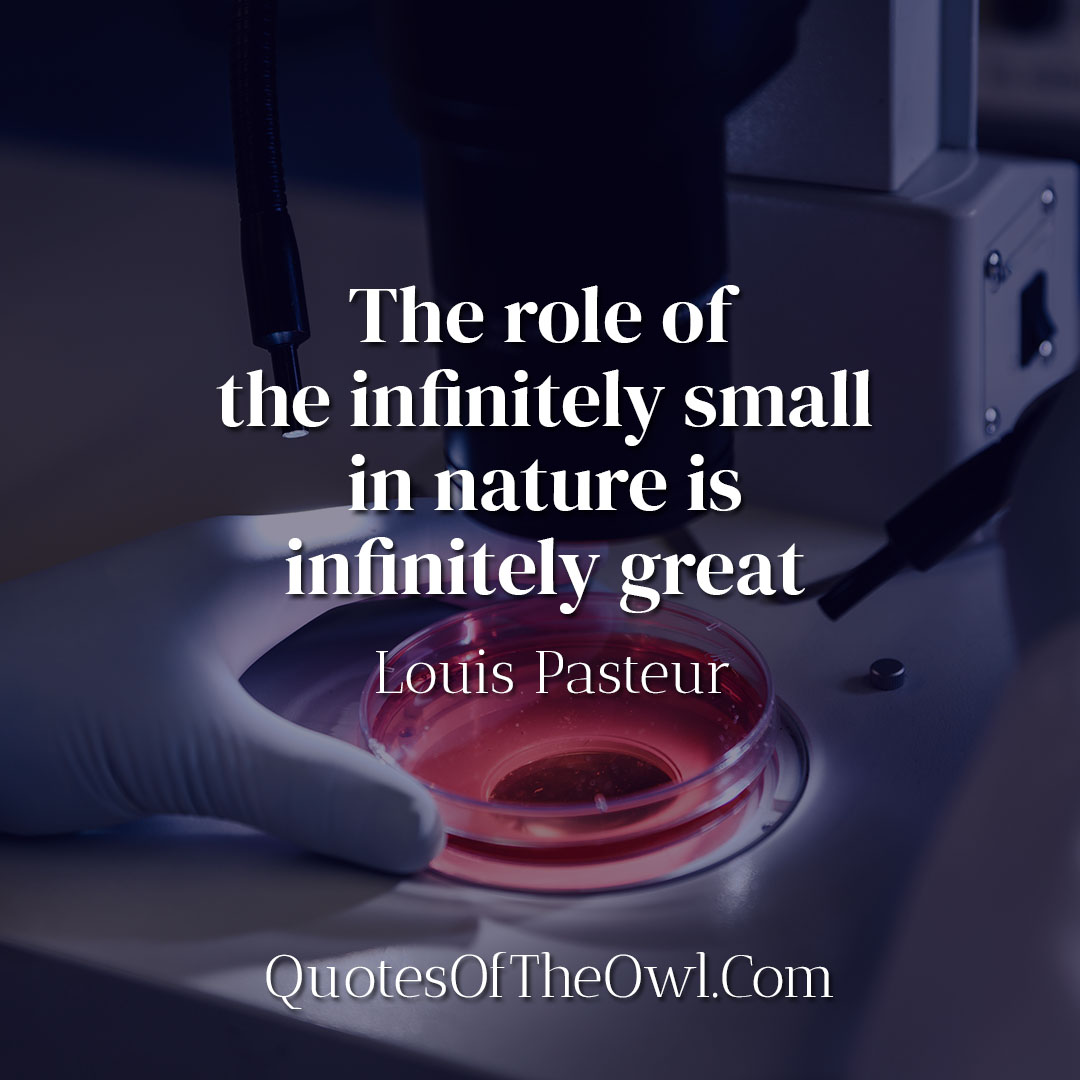
The role of the infinitely small in nature is infinitely great - Louis Pasteur

The role of the infinitely small in nature is infinitely great – Louis Pasteur’s Quote Meaning
Louis Pasteur, a renowned French biologist and chemist, once said, “The role of the infinitely small in nature is infinitely great.” These profound words encapsulate the significance of the microscopic world in shaping our natural environment and our very existence. In this article, we will delve into the meaning of this quote and explore how the “infinitely small” plays a monumental role in various aspects of nature.
Understanding the Quote
Louis Pasteur, born in 1822, is widely regarded as one of the pioneers in the field of microbiology. His groundbreaking discoveries and contributions laid the foundation for our understanding of the microscopic world.
To grasp the meaning of Pasteur’s quote, we must first comprehend the concept of the “infinitely small” in nature. This refers to microorganisms, such as bacteria, viruses, and fungi, which are invisible to the naked eye. Despite their small size, these entities hold extraordinary power in shaping the world around us.
The quote also suggests that the impact of these minute organisms extends far beyond their size. Microorganisms have the ability to alter ecosystems, influence climate patterns, and even impact the health and well-being of living organisms, including humans. By acknowledging the role of the “infinitely small,” we gain a deeper appreciation for the intricacies and interconnections within nature.
Microorganisms and Disease
Louis Pasteur’s own research focused extensively on microorganisms and their role in disease. He conducted groundbreaking experiments that established the germ theory of disease, which revolutionized medical science. Pasteur’s work provided compelling evidence that many illnesses are caused by microorganisms, challenging previous beliefs and paving the way for advancements in public health and medicine.
Microorganisms, such as pathogenic bacteria and viruses, can invade the human body, causing infections and diseases. By studying these infinitesimally small organisms, scientists have developed vaccines, antibiotics, and antiviral medications, saving countless lives and improving global health.
Industrial Applications of Microorganisms
Beyond the realm of medicine, microorganisms have a significant impact on various industries. For instance, certain bacteria and fungi are employed in the production of antibiotics, enzymes, and other pharmaceuticals. Moreover, microorganisms play a crucial role in the fermentation processes used to create a wide array of food and beverages, including bread, cheese, wine, and beer.
Additionally, microorganisms are instrumental in environmental cleanup efforts. Certain bacteria possess the remarkable ability to break down harmful substances, such as oil spills and chemical pollutants. By harnessing the power of these tiny organisms, we can mitigate the environmental impact of human activities and promote sustainability.
Environmental Importance
In the intricate web of nature, microorganisms serve as the unsung heroes of ecological balance. They participate in nutrient cycling, breaking down organic matter and releasing essential elements back into the ecosystem. Furthermore, microorganisms form symbiotic relationships with plants, aiding in nutrient absorption and enhancing their resilience against environmental stressors.
Microorganisms also play a vital role in maintaining soil health. They contribute to soil fertility by decomposing organic material and facilitating the release of nutrients that are crucial for plant growth. Without these microscopic organisms, the delicate balance of ecosystems would be disrupted, leading to cascading effects throughout the natural world.
Microorganisms and Technology
The impact of the “infinitely small” is not limited to nature alone but extends into the realm of technology as well. Scientists have harnessed the unique properties of microorganisms to develop innovative technologies. For example, certain bacteria can produce bioplastics, offering a sustainable alternative to traditional plastics derived from fossil fuels.
Moreover, researchers are exploring the potential of using microorganisms to generate clean energy. Microbes that produce biofuels through fermentation processes have the potential to revolutionize the energy sector, reducing reliance on non-renewable resources and mitigating climate change.
Microscopic World and Discoveries
Exploring the microscopic world has led to numerous groundbreaking discoveries. Scientists have unraveled the intricate structure of cells, discovered new species, and gained insights into the mechanisms of life itself. The invention of powerful microscopes has allowed us to peer into a world teeming with diverse and fascinating organisms that were previously invisible to us.
Researchers continue to uncover new aspects of the microscopic world, shedding light on fundamental biological processes and offering possibilities for future innovations. As we delve deeper into the realm of the “infinitely small,” we expand our understanding of the natural world and our place within it.
Impact on Health and Medicine
The study of microorganisms has had a profound impact on the field of health and medicine. By understanding the role of microorganisms in causing diseases, medical professionals can develop strategies for prevention, diagnosis, and treatment.
Vaccines, one of the most significant medical advancements in history, are developed based on our knowledge of microorganisms. These immunizations stimulate the body’s immune system to recognize and fight off specific pathogens, protecting individuals from diseases such as polio, measles, and influenza.
Furthermore, antibiotics have revolutionized the treatment of bacterial infections. These medications specifically target and kill harmful bacteria, allowing individuals to recover from otherwise life-threatening illnesses. However, the misuse and overuse of antibiotics have led to the emergence of antibiotic-resistant bacteria, posing a significant challenge to modern medicine.
Conclusion
Louis Pasteur’s quote, “The role of the infinitely small in nature is infinitely great,” encapsulates the profound influence of microorganisms and other minute entities in shaping the world we inhabit. From their impact on health and medicine to their contribution to various industries and the environment, the “infinitely small” plays an indispensable role in maintaining balance and driving progress.
By recognizing and understanding the significance of the microscopic world, we gain a newfound appreciation for the complexity and interconnectedness of nature. From the smallest bacterium to the vast expanse of the natural world, every element has a part to play. Let us embrace the role of the “infinitely small” and work towards harnessing its potential for the betterment of humanity and our planet.
Recommended Book: The Value of Believing in Yourself – The Story of Louis Pasteur by Spencer Johnson and Steve Pileggi